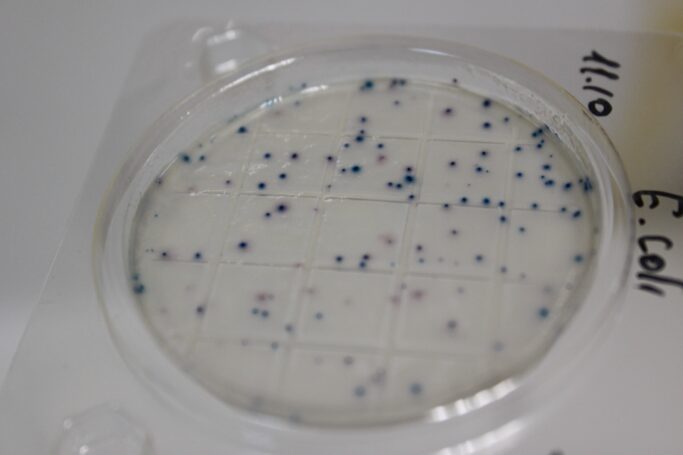
Ноу-хау от профессионалов: НПО «Альтернатива» представило «сухие» «Петритесты®»

Лента новостей
Технологии
Ноу-хау от профессионалов: НПО «Альтернатива» представило «сухие» «Петритесты®»
Группа профессиональных микробиологов научно-производственного объединения «Альтернатива» разработала и выпустила новые микробиологические экспресс-тесты «Петритесты®» на сухой среде – усовершенствованный аналог уже давно и успешно используемых тестов на агаризованной основе.
Новые тесты имеют ряд важных преимуществ, что обеспечивает их успешное применение и высокую конкурентоспособность.
Срок хранения сухих тест-пластин значительно больше, чем у традиционных, агаризованных «Петритестов®». Сухие тесты хранятся два года, причем без холодильника.
В отличие от классических методов исследования, «Петритест®» рассчитан на быстрый результат. Например, проверка на колиформные (колиморфные) бактерии в т.ч. Escherichia coli) при помощи сухих подложек «Петритест®» происходит в течение всего 24 часов.
Важным преимуществом нового «Петритеста®» является возможность определять колонии в сухой среде по цвету. Объем вносимой аликвоты равняется 1 мл – как и при классической методике исследований.
Применение Петритестов в рамках МУК 4.2.2884—11 «Методы микробиологического контроля объектов окружающей среды и пищевых продуктов с использованием петрифильмов» разрешено Роспотребнадзором.
В линейке сухих сред сегодня представлены 4 вида тест-пластин ОМЧ (КМАФАМН), Колиформные (БГКП), дрожжи/грибы/, кандида.
